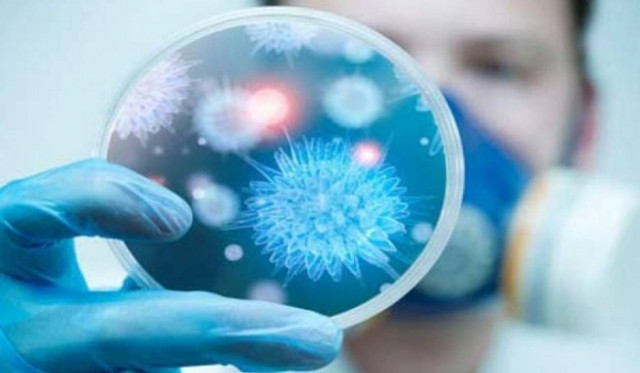
Έμπολα-Ισπανία: Αρνητικά τα αποτελέσματα των εξετάσεων για δυο ασθενείς

Έμπολα-Ισπανία: Αρνητικά τα αποτελέσματα των εξετάσεων για δυο ασθενείς
Οι ισπανικές υγειονομικές αρχές ανακοίνωσαν σήμερα ότι ένα άτομο που νοσηλευόταν με ύποπτα συμπτώματα δεν έχει προσβληθεί από τον ιό Εμπολα.
Ο άνδρας, ένας Ισπανός, ο οποίος είχε ταξιδέψει στη Νιγηρία, νοσηλευόταν μετά την επιβεβαίωση τη Δευτέρα από τις ισπανικές αρχές ότι ισπανίδα νοσοκόμος έχει προσβληθεί από τον ιό.
Αρνητική στον ιό είναι και μία δεύτερη νοσοκόμα, η οποία επίσης νοσηλευόταν με ύποπτα συμπτώματα, ενώ στο νοσοκομείο εισήχθη χθες το βράδυ και τρίτη νοσοκόμα για εξετάσεις.
Πέντε συνολικά άνθρωποι νοσηλεύονται στην Ισπανία με ύποπτα συμπτώματα. Οι εργαστηριακές εξετάσεις για τους δύο από αυτούς είναι αρνητικές.
Διαβάστε επίσης:
Έμπολα: «Το παραμικρό λάθος μπορεί να είναι θανάσιμο»
Σχόλια
Trending


Ροή Ειδήσεων
Δημοφιλή























